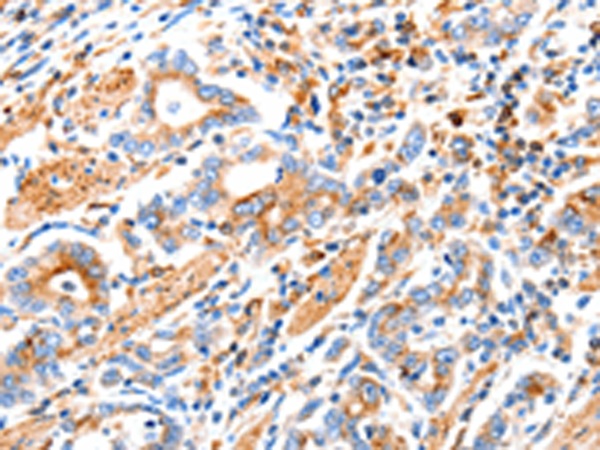

-
分类: 科研抗体货号: P04091别名: MEK2, MKK2, MAPKK2, PRKMK2应用: WB,IHC反应种属: Human, Mouse, Rat
-
分类: 科研抗体货号: P04090别名: CT1.6; MAGE6; MAGE3B; MAGE-3b应用: IHC反应种属: Human
-
分类: 科研抗体货号: P04140别名: BCL8B, LYST2应用: IHC反应种属: Human, Mouse
-
分类: 科研抗体货号: P04089别名: CT1.2; MAGE2; MAGEA2A应用: WB反应种属: Human, Mouse
-
分类: 科研抗体货号: P04189别名: NBSLD; RAD502; hRad50应用: WB,IHC反应种属: Human, Mouse, Rat
-
分类: 科研抗体货号: P04129别名: D-10, CHRNA7, CHRNA7-DR1应用: WB,IHC反应种属: Human, Mouse, Rat
-
分类: 科研抗体货号: P04088别名: U-MAF, hMafF应用: IHC反应种属: Human, Mouse
-
分类: 科研抗体货号: P04188别名:应用: WB,IHC反应种属: Human
-
分类: 科研抗体货号: P04118别名:应用: WB,IHC反应种属: Human
-
分类: 科研抗体货号: P04085别名: CD11C, SLEB6应用: IHC反应种属: Human

鄂公网安备42018502007531号
鄂公网安备42018502007531号

